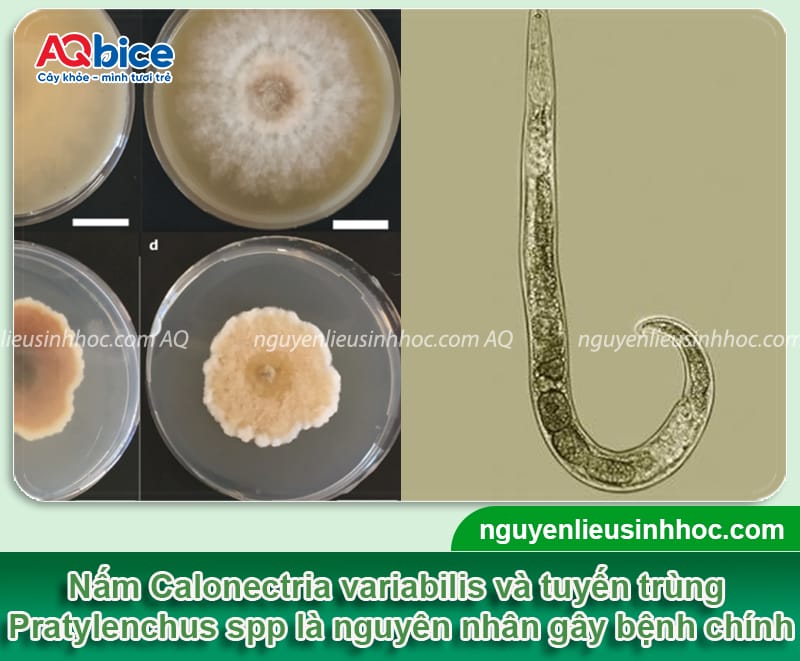
Nguyên nhân thối rễ mãng cầu xiêm và cách phòng trừ an toàn

Nguyên nhân thối rễ mãng cầu xiêm và Cách phòng trị nhanh
Kích thước chữ
Thối rễ mãng cầu xiêm là một trong những bệnh nguy hiểm nhất khiến cây vàng lá, héo rũ, rụng trái và chết khô nếu không xử lý kịp thời. Nguyên nhân chủ yếu do nấm, tuyến trùng và điều kiện úng nước kéo dài khiến bộ rễ bị thối đen, mất khả năng hấp thu dinh dưỡng.
Bệnh thường bùng phát mạnh vào mùa mưa, đặc biệt ở những vườn trồng đất thịt nặng hoặc thoát nước kém. Theo dõi bài viết dưới đây cùng Sinh học AQ để nhận biết sớm và áp dụng biện pháp canh tác, sinh học kết hợp phục hồi rễ nhằm giúp nông dân bảo vệ vườn mãng cầu xiêm khỏe mạnh, duy trì năng suất ổn định nhé.
Tìm hiểu về tình trạng thối rễ mãng cầu xiêm

Thối rễ mãng cầu xiêm đang ngày càng phổ biến ở nhiều vùng trồng, đặc biệt trong điều kiện mưa nhiều, đất ẩm kéo dài hoặc thoát nước kém. Cây bị thối rễ thường sinh trưởng chậm, lá úa vàng, cành héo rũ và có thể chết dần từ gốc lên ngọn. Nếu không phát hiện sớm và xử lý đúng cách, bệnh có thể lan nhanh toàn vườn, gây thiệt hại lớn về năng suất và tuổi thọ cây mãng cầu xiêm.
Nguyên nhân gây thối rễ mãng cầu xiêm
Nguyên nhân chính khiến rễ cây mãng cầu xiêm bị thối là do sự xâm nhập của nấm Calonectria variabilis và tuyến trùng Pratylenchus spp có trong đất trồng. Gặp điều kiện thuận lợi, tuyến trùng trong đất sẽ hoạt động, chúng sẽ cắn hại rễ gây ra những vết thương và khiến nấm xâm nhập dễ dàng.
Ngoài lý do trên, rễ mãng cầu xiêm bị thối do lạm dụng thuốc hóa học quá nhiều đặc biệt các loại thuốc làm chín trái, khai thác triệt để trái trên cây và bón phân không cân đối.
Những triệu chứng ban đầu của bệnh thối rễ mãng cầu xiêm

Một số dấu hiệu nhận biết tình trạng thối rễ mãng cầu xiêm như sau:
➡️ Lá trên cây chuyển màu sang vàng, màu sắc nhợt nhạt, có triệu chứng héo úa và rụng dần trên một vài hoặc một phần lớn tán, cành.
➡️ Cây trở nên xơ xác, còi cọc, trơ cành, dần dần cành bị chết héo, thân bị tổn thương nặng và dẫn đến chết cây.
➡️ Đào đất để kiểm tra đất thấy phần rễ tơi và rễ cái đều chuyển sang màu đen nâu hoặc đen do đang dần bị hoại tử, có mùi hôi, từng mảng đen xuất hiện gây thối rễ, làm hỏng đường dẫn quan trọng dùng để hút nước và chất dinh dưỡng.
➡️ Bệnh thường bùng phát mạnh vào mùa mưa, khi đất bị ngập úng, thoát nước kém. Ngoài ra, đất bị chua, thiếu vi khoáng hoặc mất cần bằng vi sinh có lợi cũng càng tạo điều kiện thuận lợi để bệnh nặng thêm.
Tác hại của bệnh thối rễ mãng cầu xiêm gây ra
- Bệnh thối rễ mãng cầu xiêm không chỉ làm giảm sinh trưởng mà còn ảnh hưởng nghiêm trọng đến năng suất và tuổi thọ của cây.
- Rễ bị thối, khả năng hấp thụ nước và dinh dưỡng bị suy giảm, khiến cây vàng lá, rụng trái, còi cọc và chết dần. Ở giai đoạn nhiễm nặng, mạch dẫn dinh dưỡng bị nghẽn khiến toàn bộ tán cây bị khô héo dù đất vẫn ẩm.
- Đối với vườn trồng kinh doanh, bệnh thối rễ còn gây ra thiệt hại kinh tế lớn khiến sản lượng giảm mạnh, trái nhỏ, chất lượng kém, thậm chí phải chặt bỏ toàn bộ cây bị bệnh để tránh lây lan.
- Đất trồng sau đó cũng bị ô nhiễm nấm bệnh, khó cải tạo lại nếu không xử lý đúng cách. Về lâu dài, bệnh làm suy kiệt hệ vi sinh đất, giảm hiệu quả canh tác và tăng chi phí phục hồi vườn.
Cách xử lý khi phát hiện bệnh thối rễ mãng cầu xiêm
Nếu phát hiện ra các triệu chứng của tình trạng thối rễ mãng cầu xiêm, bà con cần tiến hành xử lý nhanh, đúng kỹ thuật và theo từng bước cụ thể để cứu cây và hạn chế lây lan trong vườn như sau:
➡️ Cần quan sát phạm vi nhiễm bệnh của từng vùng như gốc, rễ và tán lá. Nếu bị nhiễm nặng, cần nhổ bỏ và tiêu hủy để tránh lây lan sang cây khác. Nếu mới chớm bị nhiễm, cây vẫn còn khả năng phục hồi, bà con tiếp tục các cách xử lý tiếp theo sau.
➡️ Cần ngừng hoàn toàn việc tưới nước, tạo rãnh thoát nước quanh gốc và luôn giữ đất đươc tơi xốp, thoáng khí.
➡️ Sau đó xới nhẹ quanh gốc, loại bỏ phần đất bị ẩm, bốc mùi, rải vôi sau xới nhằm khử khuẩn và điều chỉnh lại độ pH của đất. Phơi đất từ 2 – 3 ngày, nếu phơi vào ngày nắng ráo sẽ giảm bớt mật độ nấm bệnh.
➡️ Với những phần rễ bị bệnh, cần dùng dao cạo hoặc dùng dao sắc để cắt bỏ đoạn rễ bị thối đen, sau đó rửa rễ bằng thuốc gốc đồng như Nano Cu.
➡️ Để rễ cây được khô ráo khoảng 2 – 3 giờ, sau đó bón lại bằng hỗn hợp phân hữu cơ Trichoderma để tưới quanh vùng gốc.và phun thêm thuốc chuyên kích rễ cho cây để mau chóng phát triển nhanh.
Biện pháp phòng trừ tình trạng thối rễ mãng cầu xiêm

Muốn cây không bị nhiễm bệnh thối rễ mãng cầu xiêm, ngay từ giai đoạn đầu trước khi trồng bà con cần phải tiến hành phòng trừ ngay. Kết hợp các biện pháp canh tác để phòng trừ theo hướng bền vững, an toàn cho môi trường và cây trồng.
✅ Chọn giống sạch bệnh, khỏe mạnh, có nguồn gốc rõ ràng. Khi trồng, nên bố trí khoảng cách hợp lý (4 x 5 m/cây) để vườn luôn thông thoáng, hạn chế ẩm độ cao gây nấm bệnh phát triển.
✅ Cắt tỉa định kỳ, loại bỏ đi những cành bị sâu bệnh, khô hoặc bị vô hiệu, tiêu hủy ngay sau khi cắt để tránh lây lan mầm bệnh.
✅ Cây mãng cầu xiêm cần được bổ sung phân hữu cơ hoai mục kết hợp NPK, trung – vi lượng theo từng giai đoạn sinh trưởng, giúp rễ khỏe và tăng sức đề kháng tự nhiên.
✅ Tưới nước đủ vào những ngày nắng nóng, mùa khô đến và cần thoát nước cho cây vào mùa mưa.
✅ Để tránh bị mất nước và luôn giữ đất được ẩm bà con nên phủ gốc cho cây bằng rơm rạ, lá mãng cầu xiêm khô và cỏ khô hoặc bồi bùn.
✅ Mỗi năm bón 1 – 2 tấn vôi/ha, chia làm hai lần vào đầu và cuối mùa mưa để điều chỉnh độ pH, cải thiện cấu trúc đất và bổ sung canxi giúp rễ phát triển khỏe mạnh.
✅ Không để quá nhiều trái trên cây, tránh làm trầy xước vỏ hoặc thân; cách ly những vườn cây bị nhiễm bệnh nặng để tránh sự phát tán của nấm, tuyến trùng.
Điều trị bệnh thối rễ mãng cầu xiêm bằng thuốc hóa học
Có thể sử dụng thuốc hóa học để điều trị cây mãng cầu xiêm bị thối rễ. Trong các thành phần hóa học chứa các hoạt chất mạnh giúp phòng trừ bệnh nhanh chóng, cây mau chóng phục hồi, diệt nấm, tuyến trùng hiệu quả.
🚨 Cảnh báo: Với những ưu điểm trên nên thuốc hóa học được nhiều nhà vườn sử dụng. Nhưng thuốc hóa học cần được sử dụng đúng và đủ, nếu vượt quá mức cho phép và phụ thuộc vào nó cây trồng không những không khỏi bệnh mà bị nặng thêm và gây ra những tồn đọng nguy hiểm trong đất, nước và trong trái.
Nhiều năm trở lại đây, hiểu được những nguy hiểm mà thuốc hóa học gây ra, bà con đã và đang chuyển hướng canh tác nông nghiệp bền vững bằng cách áp dụng các phương pháp điều trị bằng thuốc sinh học vừa giúp điều trị bệnh, vừa không gây hại đến môi trường mà còn có lợi cho sức khỏe của cây.
Phòng trừ thối rễ mãng cầu xiêm bằng thuốc sinh học
Bệnh thối rễ mãng cầu xiêm do hai nguyên nhân chính là nấm và tuyến trùng gây ra. Để phòng trừ, tiêu diệt triệt để nấm, tuyến trùng mà còn giúp bảo vệ môi trường bà con tham khảo sử dụng hai dòng thuốc sinh học từ Trung tâm Sinh học AQ đó là Phy FusaCo – chuyên trị các loại nấm và Padave Cha – tiêu diệt tuyến trùng hiệu quả. Các sản phẩm đều có các thành phần sinh học an toàn, thân thiện với môi trường, điều trị về lâu dài.
Thuốc trị thối rễ mãng cầu xiêm Phy Fusaco do nấm gây ra

➡️ Thành phần:
- Chaetomium spp: 1,5×10^6CFU/ml
- Dung môi (nước cất) vừa đủ
- pH(H2O): 5; Tỷ trọng: 1,14
➡️ Công dụng:
- Phòng trừ tất cả các loại nấm gây bệnh trên cây như: Thối rễ, thán thư, nứt thân, xì mủ, thối thân, thối gốc,…
- Tăng đề kháng chống chịu lại các nấm gây bệnh, nâng cao hệ miễn dịch, hiệu quả điều trị nhanh, phổ tác động rộng.
- Thân thiện với môi trường, an toàn, không độc hại và góp phần nâng cao chất lượng nông sản.
➡️ Cách dùng: Để trị bệnh cần hòa 250ml/400 lít nước, phun kỹ toàn bộ phận cho cây, phun từ 5 – 7 ngày/lần. Để phòng bênh cần hòa 250ml vào 600 lít nước, định kỳ từ 15 – 30 ngày/lần.
Thuốc trị thối rễ trên cây mãng cầu xiêm Padave Cha do tuyến trùng

➡️ Thành phần:
- Paecilomyces lilacinus: 10^6 CFU/g, bột Talc vừa đủ.
- Thuốc được tổ hợp các chủng vi sinh vật có lợi đặc hiệu với tuyến trùng gồm có Trichoderma spp, Rhodopseudomonas sp, Chaetomium spp, Actinomycetes sp, Bacillus subtilis, Verticillium spp, Saccharomyces cerevisiae.
➡️ Công dụng:
- Tiêu diệt tuyến trùng cả trong và ngoài rễ, ngăn chúng lan rộng trong đất.
- Kích thích rễ mới phát triển, cải thiện pH đất và tăng vi sinh vật có lợi, hạn chế tuyến trùng.
- Hiệu quả bền vững, an toàn cho cây và môi trường, duy trì cân bằng sinh học, giúp cây khỏe mạnh lâu dài.
➡️ Cách dùng: Để trị tuyến trùng cần hòa 1kg thuốc vàoi 400 lít nước, tưới trực tiếp vào vùng gốc dưới tán cây, định kỳ từ 2 – 3 lần. Còn ngăn ngừa tuyến trùng cần hòa 1kg thuốc vào 800 lít nước, tưới trực tiếp vào vùng gốc dưới tán cây, định kỳ mỗi năm 3 lần.
Bài viết trên, AQ Sinh học đã cung cấp đầy đủ các thông tin tình trạng thối rễ mãng cầu xiêm như về nguyên nhân, triệu chứng nhận biết, tác hại và các cách phòng trừ hiệu quả nhất. Nếu còn những thắc mắc gì về loại bệnh này và mong muốn được sự tư vấn từ kỹ sư hãy liên hệ về tổng đài 0932 690 312, các kỹ sư của chúng tôi sẽ giải đáp tận tình cho quý nhà vườn nhé.



















